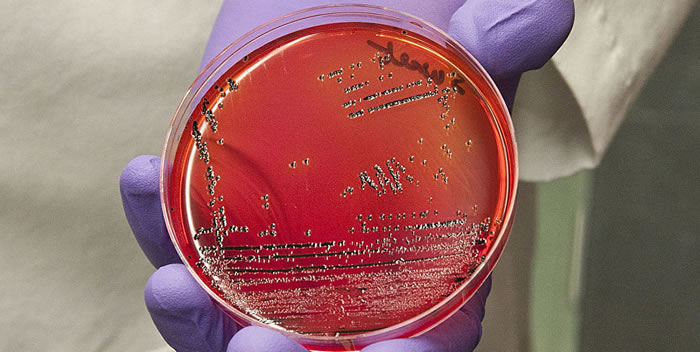
研究发现新型沙门氏菌对人类极为危险

研究发现新型沙门氏菌对人类极为危险
研究发现新型沙门氏菌对人类极为危险(© 照片: The U.S. Food and Drug Administration /Michael J. Ermarth /Public Domain)
(蜘蛛网eeook.com报道)据俄罗斯卫星网:来自比利时热带医学研究所、刚果民主共和国生物医学研究所、英国桑格研究所和剑桥大学的国际专家小组对一种新型沙门氏菌进行大规模研究,鉴定出其中一种对人类极为危险的菌株。
相关文章发表在《自然通讯》杂志。
大多数沙门氏菌感染会产生类似于食物中毒的症状。大多数情况下,沙门氏菌不会威胁生命。但某些沙门氏菌菌株,特别是在撒哈拉以南非洲常见的鼠伤寒沙门氏菌,可以引起侵入性非伤寒沙门氏菌感染(iNTS)。
侵入性非伤寒沙门氏菌感染(iNTS)是一种极为危险的传染性血液病。每年有340万人感染非伤寒沙门氏菌病,其中超过68万人死亡。由于卫生条件受限、基础设施问题、居民免疫系统薄弱,非洲此类感染的预防和治疗形势非常严峻。
大多数iNTS均由鼠伤寒沙门氏菌引起。这是一种相对新型的沙门氏菌,52年前和35年前分别从南部和中部非洲的两个病源开始传播。非洲国家最常见的是ST313菌株:它具有多重耐药性,也就是对多种抗生素具有耐药性。对人类威胁最大的是这一菌株的两个细胞亚系之一,ST313-II。
在从刚果民主共和国医院抽取的疑似iNTS血液样本进行研究时,科研人员发现了鼠伤寒沙门氏菌从未有过的抗生素耐药水平。这些细菌还对阿奇霉素具有抗药性,阿奇霉素是在最紧急的情况下使用的储备组抗生素。
遗传测序和分析结果表明,决定ST313-II亚系多药耐药性的基因存在于同一质粒中。这引起了科学家的格外担忧,因为质粒是一种可以移动的遗传要素,是小型非染色体DNA分子,可以繁殖并转移其他细胞。此类质粒转移时,此前对抗生素敏感的细胞会获得强大的耐药力。
科研人员还研究了鼠伤寒沙门氏菌如何变得"更具侵略性",从引起肠道感染转变为血液感染。研究作者之一、生物信息学专家妮可・惠勒(Nicole Wheeler)说:“我们在鼠伤寒沙门氏菌这一新的菌株组中观察到了(相同的遗传)变化,以前在其他侵入性沙门氏菌中也观察到过。”科学家计划未来基于机器学习(machine learning),创造一种预测工具来监测和跟踪多重耐药的沙门氏菌菌株。